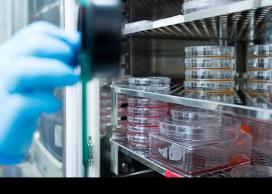
Lab materials

Updates, news and stories
A selection of updates, news and stories from across the university.
-
 UBCV & UBCOOctober 6, 2022 | Announcement | Faculty & Staff
UBCV & UBCOOctober 6, 2022 | Announcement | Faculty & StaffCentering care and supporting community-led affinity spaces in response to global events: A message from the AVP
On September 27, a university statement was posted to express concern for the situation in Iran emerging after the death of Mahsa Amini, and to acknowledge the courage of those standing up for human rights and freedoms.
-
 UBCOOctober 6, 2022 | Announcement | Faculty & Staff
UBCOOctober 6, 2022 | Announcement | Faculty & StaffAnnouncing the recipients of UBC Okanagan's Staff Awards of Excellence
Congratulations to the recipients of UBC Okanagan's 2022 Staff Awards of Excellence. At last month’s Principal and Deputy Vice-Chancellor’s Town Hall, a number of staff were recognized for their outstanding service to the university. This year, six awards were given out in the following categories: Advancing Anti-Racism and Inclusive Excellence, Enhancing the UBC Experience, Leadership, Global Citizenship, Okanagan Campus Spirit, and Wellbeing.
-
 UBCVOctober 6, 2022 | Media release | Faculty & Staff
UBCVOctober 6, 2022 | Media release | Faculty & StaffHow to protect yourself and your family this flu season
-
 UBCOOctober 5, 2022 | Okanagan Global Message | Faculty & Staff
UBCOOctober 5, 2022 | Okanagan Global Message | Faculty & StaffUpdate on Kelowna Regional Transit service resumption
-
UBCVOctober 5, 2022 | Announcement | Faculty
UBCVOctober 5, 2022 | Announcement | FacultyApply for Research Facility Support Grants by Oct. 24
The Research Facility Support Grants (RFSG) competition provides funding for the operation, maintenance, replacement, repair or upgrade of equipment used in UBC facilities to support research. The RFSGs are one-year grants of up to $50,000 intended to enhance UBC research, training, and equipment sustainability. Researchers located on the UBC Vancouver campus and affiliated hospital sites are eligible to apply by October 24, 2022.
-
 UBCOOctober 5, 2022 | Media release | Faculty & Staff
UBCOOctober 5, 2022 | Media release | Faculty & StaffNew research aims to keep planes and wind turbines ice-free
-
 UBCOOctober 5, 2022 | Okanagan Global Message | Faculty & Staff
UBCOOctober 5, 2022 | Okanagan Global Message | Faculty & StaffUpdate on Kelowna Regional Transit service disruption
-
UBCV & UBCOOctober 4, 2022 | UBC Broadcast | Faculty & Staff
Support this year’s UBC United Way campaign
A message from Santa J. Ono, President and Vice-Chancellor; Lesley Cormack, Deputy Vice-Chancellor and Principal, UBC Okanagan
-
 UBCVOctober 4, 2022 | Media release | Faculty & Staff
UBCVOctober 4, 2022 | Media release | Faculty & StaffThe right computer password can offer a mental health ‘booster’
-
 UBCVOctober 3, 2022 | Announcement | Faculty & Staff
UBCVOctober 3, 2022 | Announcement | Faculty & StaffCall for applications: Campus as a Living Lab Fund Competition
Campus as a Living Lab (CLL) offers faculty and staff at UBC Vancouver an opportunity to explore, develop and test new ideas on sustainability and climate action on campus. The 2022/23 CLL Fund Competition provides up to $50,000 in funding for teams to develop 'living lab' projects. The deadline to submit proposals is November 7.
-
UBCV & UBCOOctober 3, 2022 | UBC Broadcast | Faculty & Staff
UBC appoints Dr. Deborah Buszard as Interim President and Vice-Chancellor
A message from Nancy McKenzie, Chair, UBC Board of Governors
-
 UBCVOctober 3 | Feature story | Faculty & Staff
UBCVOctober 3 | Feature story | Faculty & StaffNecessity is the mother of a delicious invention
Gerry Kasten and Joel Barohn are breaking down barriers and redefining how students learn to cook at UBC
